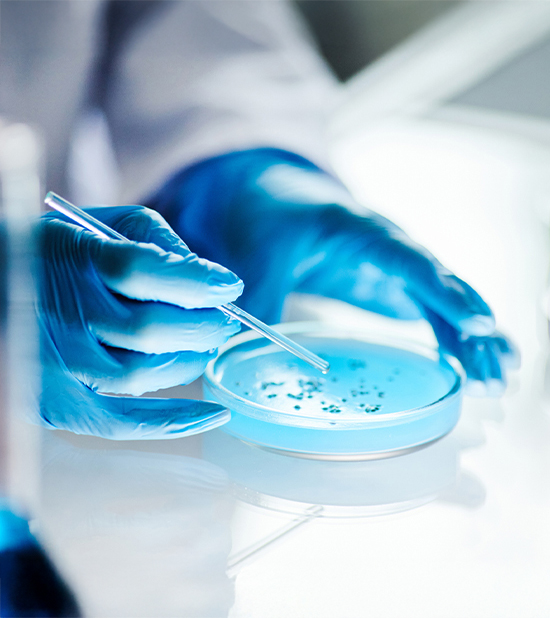
iStock-2176475781 iStock-2176475781

Science-Ready Supply
A Strategic Approach
Every lab faces familiar challenges—rising costs, unpredictable supply chains, and the pressure to do more with less. Traditional procurement models often make it worse, driven by supplier incentives rather than scientific priorities. Pacer changes that dynamic with a strategy built entirely around your lab’s goals.
Every product supplied through the Pacer program is selected to deliver equal or greater value than previously sourced alternatives. We supply products directly only when they create measurable benefit for customers through improved pricing, availability, sustainability, or service. The program’s built-in transparency provides the visibility and oversight customers need to confidently outsource day-to-day purchasing, while giving Pacer the autonomy to execute approved sourcing strategies that maximize overall value.
By leveraging decades of experience, deep supplier partnerships, and genuine care for our customers, we remove barriers between research and results—so you get what you need, when you need it, without compromise.
Customization
Pricing
Strategies
The Freedom to Choose. Confidence
Redefining Procurement, Delivering Results. Delays, over-ordering, and supply disruptions aren’t just inconvenient—they can stall discovery. Pacer’s proactive, data-driven approach ensures reliability, responsiveness, and results. We combine intelligence and action to keep your lab stocked, supported, and ready for whatever comes next.
The Science of Cost Savings
Our data-driven model optimizes spend without limiting choice.
- Leveraging Partnerships: Strong manufacturer relationships deliver competitive discounts—and we pass those savings directly to you.
- Bulk Buys, Smarter Storage: We secure cost advantages through bulk purchasing and local off-site storage, eliminating clutter and extending savings.
- Reducing Transaction Fees: By centralizing procurement, we eliminate duplicate orders, minimize fees, and give your financial team full visibility into every dollar spent.
Results You Can Measure
Pacer’s strategic procurement process doesn’t just look good on paper—it performs in practice. Through smarter sourcing and transparent reporting, our clients experience:
- Enhanced Efficiency: Stockouts are eliminated and inventory levels align with actual consumption
- Reliable Access: Proactive planning ensures critical materials are always available when you need them
- Research Empowerment: Scientists reclaim time to focus on breakthroughs instead of backorders